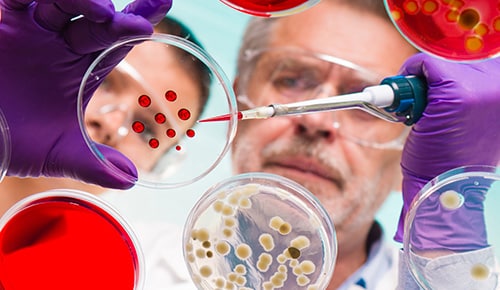
Formation matériaux et produits formules en alternance IUT de Béthune

Mathilde BELLANGER
Chargée de missions apprentissage
06 21 09 75 79
m.bellanger@afi24.org
- Analyse, contrôle qualité, environnement
- Chimie Industrielle – Procédés et Bio-procédés
- synthèse
- Matériaux et produits formulés – Matériaux inorganiques
Date d'enregistrement certification RNCP : 18/03/2021 | RNCP35497 | Code diplôme : 25122202

| Inscription | Rentrée | Durée de la formation |
| Ouverture des inscriptions : 15/01/2025 fin des inscriptions : |
||
2ème année : 31/07/2025 |
01/09/2025 | 1205 heures / 2 ans |
3ème année : 31/05/2025 |
15/09/2025 | 430 heures / 1 an |
| Rythme d'alternance |
2ème année : Pour la 2ème année de BUT : 2 semaines en formation – 2 semaines en entreprise. Pour la 3ème année de BUT : 1 mois en formation – 1 mois en entreprise. |
3ème année : 4 semaines / 4 semaines |
Contact établissement
Marine DE PERSON
Responsable de la formation
marine.de-person@u-psud.fr
Christelle TURCHIULI
Responsable formation
christelle.turchiuli@agroparistech.fr
Conditions d'inscription
Jeune ayant moins de 30 ans à la signature du contrat d'apprentissage.
Modalités
Modalité(s) d'évaluation :
Examens en Contrôle continu, rapports et soutenances.
Modalités pédagogiques :
Cours théoriques / Travaux pratiques / Travaux dirigés / Projets.
Procédure de recrutement :
Candidatures internes IUT d'Orsay : Étude du dossier en interne + dépôt de CV
Candidatures externes : Étude du dossier (CV, lettre de motivation, relevés de notes) et entretien de motivation.
| Résultat examen : | 100% | |
| Poursuite d'études : | Non Disponible | |
| Insertion professionnelle : | Non Disponible | |
| Rupture de contrat : | 50% | |
| Rupture de parcours : | 50% |
Chimie Industrielle – Procédés et Bio-procédés
- ANNÉE 2
- ANNÉE 3
La formation comporte 1205 h d’enseignement dont 40 % environ de travaux pratiques.
Le BUT2 généraliste est découpé en 6 blocs de compétences (analyser, synthétiser, élaborer, produire, gérer et contrôler).
La spécialisation se fait en BUT3 où le programme se découpe, pour les 2 semestres, en 3 blocs de compétences (« produire », « gérer » et « contrôler »).
Le premier bloc de compétences (« Produire ») représente le cœur de métier de la formation et contient les ressources suivantes détaillées ci-après :
Programme 2eme année :
Contact pour la 2ème année : Marine de Person (marine.de-person@universite-paris-saclay.fr / 01.69.33.61.34)
UE3.1 et UE4.1 Analyser les échantillons solides, liquides et gazeux
- Méthodes séparatives et caractérisation structurale
- Méthodes spectrométriques
- Analyses expérimentales
- Electrochimie appliquée
- Techniques électrochimiques appliquées à l’analyse
- Physique appliquée à l’analyse
- Projet Professionnel Personnalisé (PPP)
- Projet
- SAé (heures spécifiques)
UE3.2 et UE4.2 Synthétiser des molécules
- Synthèse organique
- Synthèse multi-étape
- Synthèse inorganique
- Mise en œuvre des techniques de synthèse inorganique
- Projet Professionnel Personnalisé (PPP)
- Projet
- SAé (heures spécifiques)
UE3.3 et UE4.3 Élaborer des matériaux et/ou des produits formulés
- Matériaux organiques
- Matériaux inorganiques
- Priorités des matériaux et formulation
- Elaboration / formulation et caractérisation matériaux et produits formulés
- Démarche qualité – développement durable – écoconception
- Electrochimie appliquée
- Techniques électrochimlques appliquées
- Projet Professionnel Personnalisé (PPP)
- Projet
- SAé (heures spécifiques)
UE3.4 et UE4.4 Produire des composés intermédiaires et des produits finis
- Opérations unitaires et séparation
- Mise en œuvre d’opérations unitaires de séparation
- Chimiométrie Probabilités Statistiques
- Physique instrumentale
- Réacteurs chimiques homogènes
- Introduction aux bioprocédés : séchage et transfert
- Projet Professionnel Personnalisé (PPP)
- Projet
- SAé (heures spécifiques)
UE3.5 et UE4.5 Gérer un laboratoire de chimie ou un atelier de production
- Anglais
- Expression communication – Connaissance de l’entreprise
- Développement durable : état des lieux
- Mathématiques appliquées
- Projet Professionnel Personnalisé (PPP)
- Projet
- SAé (heures spécifiques)
UE3.6 et UE 4.6 Contrôler les aspects Hygiène, Sécurité, Environnement
- Physique instrumentale
- Développement durable : état des lieux - écoconception
- Mathématiques appliquées
- Projet Professionnel Personnalisé (PPP)
- Projet
- SAé (heures spécifiques)
Programme
La formation comporte 430 h d’enseignement dont 40 % environ de travaux pratiques.
Le BUT3 correspond à l'année de spécialisation en Procédés et Bioprocédés du BUT Chimie. Le programme se découpe, pour les 2 semestres, en 3 blocs de compétences (« produire », « gérer » et « contrôler »).
Produire des composés intermédiaires et des produits finis
- Procédés innovants et avancés : Microbiologie industrielle, Bioréacteurs, Valorisation des bioressources
- Conduite et simulation des procédés : outils numériques pour l’exploitation des données, Opérations de stabilisation et de mise en forme
- Analyses pour la production : Caractérisation des propriétés physico-chimiques des bioproduits, Analyse des biomolécules
- Procédés multiphasiques et réactifs : Extraction et Séparation des biomolécules par des procédés chimiques, physico-chimiques et thermomécaniques, Techniques séparatives sur membranes, chromatographie préparative
- Mise en œuvre des procédés : Travaux pratiques de Valorisation des bioressources et amélioration des procédés, Bioprocédés, Techniques séparatives et Opérations de stabilisation, Caractérisation des bioproduits et Analyse des biomolécules
- Physique instrumentale : Capteurs, biocapteurs
- Portefolio
Gérer un laboratoire de chimie ou un atelier de production
- Expression communication : Préparation au projet professionnel
- Anglais : Préparation à la certification en anglais
- Connaissance de l'entreprise et du droit : Bonnes pratiques, Bioéconomie : enjeux sociétaux et environnementaux, entreprenariat
Contrôler les aspects Hygiène, Sécurité, Environnement
- Techniques séparatives pour la production
- Démarche sécurité
- Management par la qualité
PPP
SAé Alternance
Date d'enregistrement certification RNCP : 18/03/2021 | RNCP35495 | Code diplôme : 25122204
| Inscription | Rentrée | Durée de la formation |
| Ouverture des inscriptions : 15/01/2025 fin des inscriptions : |
||
2ème année : 31/07/2025 |
01/09/2025 | 1205 heures / 2 ans |
3ème année : 31/07/2025 |
08/09/2025 | 430 heures / 1 an |
| Rythme d'alternance |
2ème année : Pour la 2ème année de BUT : 2 semaines en formation – 2 semaines en entreprise. Pour la 3ème année de BUT : 1 mois en formation – 1 mois en entreprise. |
3ème année : 4 semaines / 4 semaines |
Contact établissement
Marine DE PERSON
Responsable de la formation
marine.de-person@u-psud.fr
Giang VO THANH
Responsable de la formation
Giang.Vo-Thanh@u-psud.fr
Conditions d'inscription
Jeune ayant moins de 30 ans à la signature du contrat d'apprentissage.
Modalités
Modalité(s) d'évaluation :
Evaluation en Contrôle continu, rapports et soutenances.
Modalités pédagogiques :
Cours théoriques / Travaux pratiques / Travaux dirigés
Procédure de recrutement :
Candidatures internes à l'IUT d'Orsay : Étude du dossier en interne + dépôt CV
Candidatures externes : Étude du dossier (CV, lettre de motivation, relevés de notes) et entretien de motivation.
| Résultat examen : | 88% | |
| Poursuite d'études : | Non Disponible | |
| Insertion professionnelle : | Non Disponible | |
| Rupture de contrat : | 7% | |
| Rupture de parcours : | 7% |
synthèse
- ANNÉE 2
- ANNÉE 3
Programme
La formation comporte 1205 h d’enseignement dont 40 % environ de travaux pratiques.
Le BUT2 généraliste est découpé en 6 blocs de compétences (analyser, synthétiser, élaborer, produire, gérer et contrôler).
La spécialisation se fait en BUT3 où le programme se découpe, pour les 2 semestres, en 3 blocs de compétences (« Synthétiser », « gérer » et « contrôler »).
Le premier bloc de compétences (« Synthétiser ») représente le cœur de métier de la formation et contient les ressources suivantes détaillées ci-après :
Programme 2eme année :
Contact pour la 2ème année : Marine de Person (marine.de-person@universite-paris-saclay.fr / 01.69.33.61.34)
UE3.1 et UE4.1 Analyser les échantillons solides, liquides et gazeux
- Méthodes séparatives et caractérisation structurale
- Méthodes spectrométriques
- Analyses expérimentales
- Electrochimie appliquée
- Techniques électrochimiques appliquées à l’analyse
- Physique appliquée à l’analyse
- Projet Professionnel Personnalisé (PPP)
- Projet
- SAé (heures spécifiques)
UE3.2 et UE4.2 Synthétiser des molécules
- Synthèse organique
- Synthèse multi-étape
- Synthèse inorganique
- Mise en œuvre des techniques de synthèse inorganique
- Projet Professionnel Personnalisé (PPP)
- Projet
- SAé (heures spécifiques)
UE3.3 et UE4.3 Élaborer des matériaux et/ou des produits formulés
- Matériaux organiques
- Matériaux inorganiques
- Priorités des matériaux et formulation
- Elaboration / formulation et caractérisation matériaux et produits formulés
- Démarche qualité – développement durable – écoconception
- Electrochimie appliquée
- Techniques électrochimlques appliquées
- Projet Professionnel Personnalisé (PPP)
- Projet
- SAé (heures spécifiques)
UE3.4 et UE4.4 Produire des composés intermédiaires et des produits finis
- Opérations unitaires et séparation
- Mise en œuvre d’opérations unitaires de séparation
- Chimiométrie Probabilités Statistiques
- Physique instrumentale
- Réacteurs chimiques homogènes
- Introduction aux bioprocédés : séchage et transfert
- Projet Professionnel Personnalisé (PPP)
- Projet
- SAé (heures spécifiques)
UE3.5 et UE4.5 Gérer un laboratoire de chimie ou un atelier de production
- Anglais
- Expression communication – Connaissance de l’entreprise
- Développement durable : état des lieux
- Mathématiques appliquées
- Projet Professionnel Personnalisé (PPP)
- Projet
- SAé (heures spécifiques)
UE3.6 et UE 4.6 Contrôler les aspects Hygiène, Sécurité, Environnement
- Physique instrumentale
- Développement durable : état des lieux - écoconception
- Mathématiques appliquées
- Projet Professionnel Personnalisé (PPP)
- Projet
- SAé (heures spécifiques)
Le programme
Formation de 430 h dont 150 h environ de travaux pratiques
La formation comporte 430 h d’enseignement dont 35 % environ de travaux pratiques.
Le programme se découpe, pour les 2 semestres, en 3 blocs de compétences (UE5.2 « synthétiser », UE5.5 « gérer » et UE5.6 « contrôler »).
UE5.2 Synthétiser des molécules
- Synthèse organique : Chimie organique fondamentale et rétrosynthèse, Chimie éco-compatible, Catalyses organométallique, organique et enzymatique, Chiralité, Glycochimie, chimie des groupements protecteurs
- Chimie de la vie : Chimie du vivant et polymères organiques, Chimie hétérocyclique et chimie des médicaments
- Physique instrumentale
- PPP (Projet Personnel et Professionnel)
UE5.5 Gérer un laboratoire de chimie ou un atelier de production
- Expression communication
- Anglais : préparation au TOEIC
- Connaissance de l'entreprise de droit
- Management par la qualité
UE5.6 Contrôler les aspects Hygiène, Sécurité, Environnement
- Outils analytiques pour la synthèse : Méthodes séparatives, chromatographie, Méthodes d’analyse : RMN, Spectrométrie de Masse
- Démarche sécurité : Formations SST et HSE
- Management de la qualité : Gérer des activités de laboratoire de chimie
- Contrôle des aspects Hygiène, Sécurité, Environnement
SAé Alternance
Portefolio
Date d'enregistrement certification RNCP : 18/03/2021 | RNCP35496 | Code diplôme : 25122203

| Inscription | Rentrée | Durée de la formation |
| Ouverture des inscriptions : 15/01/2025 fin des inscriptions : |
||
2ème année : 31/07/2025 |
01/09/2025 | 1205 heures / 2 ans |
3ème année : 30/06/2025 |
08/09/2025 | 430 heures / 1 an |
| Rythme d'alternance |
2ème année : Pour la 2ème année de BUT : 2 semaines en formation – 2 semaines en entreprise. Pour la 3ème année de BUT : 1 mois en formation – 1 mois en entreprise. |
3ème année : 4 semaines / 4 semaines |
Contact établissement
Marine DE PERSON
Responsable de la formation
marine.de-person@u-psud.fr
Lionel Tinat
Responsable de la formation
chim3a-mat.iut-orsay@universite-paris-saclay.fr
Jean-François Olivieri
Responsable de la formation
chim3a-mat.iut-orsay@universite-paris-saclay.fr
Conditions d'inscription
Jeune ayant moins de 30 ans à la signature du contrat d'apprentissage.
Modalités
Modalité(s) d'évaluation :
Evaluation en Contrôle continu, rapports et soutenances.
Modalités pédagogiques :
Cours théoriques / Travaux pratiques / Travaux dirigés / Projets.
Procédure de recrutement :
Candidatures internes IUT d'Orsay : Étude du dossier en interne + dépôt de CV
Candidatures externes : Étude du dossier (CV, lettre de motivation, relevés de notes) et entretien de motivation.
| Résultat examen : | 100% | |
| Poursuite d'études : | Non Disponible | |
| Insertion professionnelle : | Non Disponible | |
| Rupture de contrat : | 13% | |
| Rupture de parcours : | 0% |
Matériaux et produits formulés – Matériaux inorganiques
- ANNÉE 2
- ANNÉE 3
Programme
La formation comporte 1205 h d’enseignement dont 40 % environ de travaux pratiques.
Le BUT2 généraliste est découpé en 6 blocs de compétences (analyser, synthétiser, élaborer, produire, gérer et contrôler).
La spécialisation se fait en BUT3 où le programme se découpe, pour les 2 semestres, en 3 blocs de compétences (« Elaborer », « gérer » et « contrôler »).
Le premier bloc de compétences (« Elaborer ») représente le cœur de métier de la formation et contient les ressources suivantes détaillées ci-après :
Programme 2eme année :
Contact pour la 2ème année : Marine de Person (marine.de-person@universite-paris-saclay.fr / 01.69.33.61.34)
UE3.1 et UE4.1 Analyser les échantillons solides, liquides et gazeux
- Méthodes séparatives et caractérisation structurale
- Méthodes spectrométriques
- Analyses expérimentales
- Electrochimie appliquée
- Techniques électrochimiques appliquées à l’analyse
- Physique appliquée à l’analyse
- Projet Professionnel Personnalisé (PPP)
- Projet
- SAé (heures spécifiques)
UE3.2 et UE4.2 Synthétiser des molécules
- Synthèse organique
- Synthèse multi-étape
- Synthèse inorganique
- Mise en œuvre des techniques de synthèse inorganique
- Projet Professionnel Personnalisé (PPP)
- Projet
- SAé (heures spécifiques)
UE3.3 et UE4.3 Élaborer des matériaux et/ou des produits formulés
- Matériaux organiques
- Matériaux inorganiques
- Priorités des matériaux et formulation
- Elaboration / formulation et caractérisation matériaux et produits formulés
- Démarche qualité – développement durable – écoconception
- Electrochimie appliquée
- Techniques électrochimlques appliquées
- Projet Professionnel Personnalisé (PPP)
- Projet
- SAé (heures spécifiques)
UE3.4 et UE4.4 Produire des composés intermédiaires et des produits finis
- Opérations unitaires et séparation
- Mise en œuvre d’opérations unitaires de séparation
- Chimiométrie Probabilités Statistiques
- Physique instrumentale
- Réacteurs chimiques homogènes
- Introduction aux bioprocédés : séchage et transfert
- Projet Professionnel Personnalisé (PPP)
- Projet
- SAé (heures spécifiques)
UE3.5 et UE4.5 Gérer un laboratoire de chimie ou un atelier de production
- Anglais
- Expression communication – Connaissance de l’entreprise
- Développement durable : état des lieux
- Mathématiques appliquées
- Projet Professionnel Personnalisé (PPP)
- Projet
- SAé (heures spécifiques)
UE3.6 et UE 4.6 Contrôler les aspects Hygiène, Sécurité, Environnement
- Physique instrumentale
- Développement durable : état des lieux - écoconception
- Mathématiques appliquées
- Projet Professionnel Personnalisé (PPP)
- Projet
- SAé (heures spécifiques)
Programme
La troisième année du BUT chimie matériaux et produits formulés comporte 430 h d’enseignement dont environ 150 h de travaux pratiques (35 % du volume total).
Unité d’enseignement 3 : Élaborer des matériaux et/ou des produits formulés– 330 h
- Matériaux pour l’énergie
- Elaboration avancée de matériaux
- Caractérisations et analyses
- Durabilité des matériaux
- Relation structures et propriétés des matériaux
- Méthodes expérimentales avancées d’élaboration de matériaux
- Physique appliquée aux matériaux
- Ecoconception et recyclage des matériaux
- Méthodes de caractérisation
Unité d’enseignement 5 : Gérer un laboratoire de chimie ou un atelier de production - 50h
- Expression communication
- Anglais
- Connaissance de l’entreprise et du droit
- HSEQ
- Droit du travail et lutte contre les discriminations
Unité d’enseignement 6 : Contrôler les aspects Hygiène, Sécurité, Environnement - 50h
- Statistique - Chimiométrie
- Droit du travail et lutte contre les discriminations
- Démarche sécurité
- Management par la qualité
- HSEQ
SAé Alternance
Portefolio


